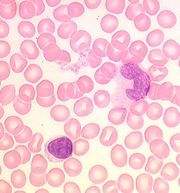

Uploads by Ctrace
Jump to navigation
Jump to search
This special page shows all uploaded files.
| Date | Name | Thumbnail | Size | Description | Versions |
|---|---|---|---|---|---|
| 11:48, 3 May 2011 | English link.png (file) |  |
11 KB | {{Information |Description =Image of the link on es.wikvet.net to content on WikiVet |Source =es.wikivet.net |Author =Chris Trace |Date =03/05/2011 |Permission = |other_versions = }} | 1 |
| 11:42, 3 May 2011 | Espanol link.png (file) |  |
1 KB | {{Information |Description =An image of the links to Spanish WikiVet |Source =WikiVet |Author =Chris Trace |Date =03/05/2011 |Permission = |other_versions = }} | 1 |
| 08:58, 3 May 2011 | Gemma crop.jpg (file) |  |
8 KB | {{Information |Description =Cropped image of photo of Gemma and her dogs |Source =cropped version of Gemma's photo |Author =Chris Trace |Date =03/05/2011 |Per | 1 |
| 10:22, 20 April 2011 | ScottCover.png (file) |  |
62 KB | {{Information |Description =Screen shot of [http://www.mansonpublishing.com/vet_titles/ScottSACR.html Cattle and Sheep Medicine] SACR by Manson Publishing. Used as part of the OVAL Project |Source =Manson Publishing |Author =Chris | 1 |
| 10:30, 17 April 2011 | RVC.jpg (file) |  |
41 KB | {{Information |Description =The RVC updated logo |Source =Royal Veterinary College |Author =RVC |Date =2010 |Permission = |other_versions = }} | 1 |
| 08:02, 13 April 2011 | Issue4.jpg (file) |  |
73 KB | {{Information |Description =screenshot of WikiVet newsletter Issue 4 |Source =WikiVet newsletter Issue 4 |Author =Chris Trace |Date =newsletter sent 7th April 2011 |Permission = |other_versions = }} | 1 |
| 07:55, 13 April 2011 | April 2001 Issue 4.pdf (file) | 137 KB | {{Information |Description =4th Issue of the WikiVet newsletter |Source =WikiVet |Author =Chris Trace |Date =Sent 7th April 2011 |Permission = |other_versions = }} | 1 | |
| 14:03, 6 April 2011 | Tetralogy of Fallot.jpg (file) |  |
57 KB | {{Information |Description =Screenshot from Sheep Tetralogy of Fallot video |Source =Edinburgh Vet School |Author =Rod Else and Susan Rhind |Date =uploaded to W | 1 |
| 18:56, 5 April 2011 | Murcia Visit.jpg (file) |  |
71 KB | {{Information |Description =A photo of the vet students from Murcia visiting the Royal Veterinary College and the WikiVet team |Source =WikiVet |Author =Gemma Gaitskell-Phillips |Date =02/04/2011 |Permission = |other_versi | 1 |
| 15:01, 5 April 2011 | Cattle Medicine 7.jpg (file) |  |
282 KB | {{Information |Description =Image from [http://www.mansonpublishing.com/vet_titles/ScottSACR.html 'Cattle and Sheep Medicine'], with permission from Manson Publishing, as part of the OVAL Project. This is an image of a calf with Meningi | 1 |
| 16:26, 4 April 2011 | OVAL.png (file) |  |
22 KB | {{Information |Description=Opening Veterinary Access to Literature (OVAL) project logo |Source=Royal Veterinary College |Date=March 2011 |Author=B. Cox |Permission=See below |other_versions= }} | 1 |
| 15:53, 4 April 2011 | Videoshadow.png (file) |  |
87 KB | {{Information |Description=Videos logo with shadow effect |Source=WikiVet |Date=04/04/2011 |Author=Chris Trace |Permission=All rights reserved. |Other_versions= }} | 1 |
| 15:19, 4 April 2011 | Flashcards logo.png (file) |  |
54 KB | {{Information |Description=Flashcards logo |Source=RVC |Date=04/04/2011 |Author=Brian Cox |Permission=All rights reserved. |Other_versions= }} | 1 |
| 15:07, 4 April 2011 | Issue3.png (file) |  |
349 KB | {{Information |Description=Screenshot of Issue 3 of WV newsletter |Source=WikiVet |Date=sent 8th March 2011 |Author=Chris Trace |Permission=All rights reserved. |Other_versions= }} | 1 |
| 14:51, 2 April 2011 | MurciaLogo.png (file) |  |
18 KB | {{Information |Description=University of Murcia Logo, taken from [http://commons.wikimedia.org/wiki/File:Universitas_Studiorum_Murciana_b-w.png WikiMedia Commons] |Source=[http://commons.wikimedia.org/wiki/File:Universitas_Studiorum_Murciana_b-w.png WikiM | 1 |
| 18:44, 1 April 2011 | Cattle Medicine 6.jpg (file) |  |
225 KB | {{Information |Description=Image from [http://www.mansonpublishing.com/vet_titles/ScottSACR.html 'Cattle and Sheep Medicine'], with permission from Manson Publishing, as part of the OVAL Project. This is an image of a cow with nasal discha | 1 |
| 18:34, 1 April 2011 | Cattle Medicine 5.jpg (file) |  |
231 KB | {{Information |Description=Image from [http://www.mansonpublishing.com/vet_titles/ScottSACR.html 'Cattle and Sheep Medicine'], with permission from Manson Publishing, as part of the OVAL Project. This is an image of a cow with bilateral na | 1 |
| 18:20, 1 April 2011 | Cattle Medicine 4.jpg (file) |  |
315 KB | {{Information |Description=Image from [http://www.mansonpublishing.com/vet_titles/ScottSACR.html 'Cattle and Sheep Medicine'], with permission from Manson Publishing, as part of the OVAL Project. This is an image of a group of calves with | 1 |
| 18:07, 1 April 2011 | Cattle Medicine 3.jpg (file) |  |
356 KB | {{Information |Description=Image from [http://www.mansonpublishing.com/vet_titles/ScottSACR.html 'Cattle and Sheep Medicine'], with permission from Manson Publishing, as part of the OVAL Project. This is an image of a Uterine Prolapse |Sou | 1 |
| 17:52, 1 April 2011 | Cattle Medicine 2.jpg (file) |  |
332 KB | {{Information |Description=Image from [http://www.mansonpublishing.com/vet_titles/ScottSACR.html 'Cattle and Sheep Medicine'], with permission from Manson Publishing, as part of the OVAL Project. This is an image of a digit being amputated | 1 |
| 17:33, 1 April 2011 | Cattle Medicine 1.jpg (file) |  |
259 KB | {{Information |Description=Image from [http://www.mansonpublishing.com/vet_titles/ScottSACR.html 'Cattle and Sheep Medicine'], with permission from Manson Publishing, as part of the OVAL Project. This is an image of a Ketotic cow |Source=[ | 1 |
| 14:20, 29 March 2011 | NOVICE.png (file) |  |
7 KB | {{Information |Description=screenshot of NOVICE logo |Source=www.noviceproject.eu |Date=29/03/2011 |Author=Chris Trace |Permission=See below |Other_versions= }} | 1 |
| 12:19, 29 March 2011 | Show original.png (file) |  |
266 KB | {{Information |Description=Screenshot of 'show original' google translate button, arrowed |Source=WikiVet |Date=29/03/2011 |Author=Chris Trace |Permission=See below |Other_versions= }} | 1 |
| 12:08, 29 March 2011 | Translate.png (file) |  |
18 KB | {{Information |Description=Screenshot of Google Translate extension on WikiVet page |Source=WikiVet |Date=29/03/2011 |Author=Chris Trace |Permission=See below |Other_versions= }} | 1 |
| 14:51, 25 March 2011 | Blood and haemopoiesis.jpg (file) | |
36 KB | {{Information |Description=Screenshot from Powerpoint, courtesy of the Royal Veterinary College |Source=The Royal Veterinary College |Date=25/03/2011 |Author=Chris Trace |Permission=See below |Other_vers | 1 |
| 13:00, 22 March 2011 | March 2011 Issue 3.pdf (file) | 574 KB | {{Information |Description=March 2011 Issue 3 of WikiVet newsletter in PDF format |Source=WikiVet |Date=sent 8th March 2011 |Author=Chris Trace |Permission=See below |Other_versions= }} | 1 | |
| 17:39, 18 March 2011 | Connective Tissue.png (file) |  |
1.01 MB | {{Information |Description=Screenshot from Powerpoint, courtesy of the Royal Veterinary College |Source=The Royal Veterinary College |Date=18/03/2011 |Author=Chris Trace |Permission=See below |Other | 1 |
| 13:32, 18 March 2011 | Thyroid gland.png (file) |  |
986 KB | {{Information |Description=screenshot from the Epithelial Histology resource featuring an image of the thyroid gland |Source=Epithelial Histology resource, courtesy of the RVC |Date=18/03/2011 |Author=Chris Trace |Permission=See below |Other_v | 1 |
| 11:24, 18 March 2011 | Introductory Histology.swf (file) | 779 KB | {{Information |Description=Introduction to histology PowerPoint converted into swf |Source=RVC |Date= |Author=RVC |Permission=See below |Other_versions= }} | 1 | |
| 17:43, 17 March 2011 | OcularReflexes.png (file) |  |
936 KB | {{Information |Description=a screenshot of the Ocular Reflexes resource |Source=[http://www.rvc.ac.uk/Review/OcularReflexes.cfm eMedia showcase, Royal Veterinary College] |Date=17/03/2011 |Author=Chris Trace |Permission=See below |Other_versions= }} | 1 |
| 17:34, 17 March 2011 | OcularReflexes.jpg (file) |  |
72 KB | {{Information |Description=a screenshot of the Ocular Reflexes resource |Source=[http://www.rvc.ac.uk/Review/OcularReflexes.cfm eMedia showcase, Royal Veterinary College] |Date=17/03/2011 |Author=Chris Trace |Permission=See below |Other_versions= }} | 1 |
| 18:09, 16 March 2011 | February 2011 Issue 2.pdf (file) | 208 KB | {{Information |Description=Issue 2 of WV newsletter |Source=WikiVet |Date=February 2011 |Author=Chris Trace |Permission=See below |Other_versions= }} | 1 | |
| 18:06, 16 March 2011 | Issue 1.pdf (file) | 122 KB | {{Information |Description=Issue 1 of WikiVet newsletter |Source=WikiVet |Date=18th December 2011 |Author=Chris Trace |Permission=See below |Other_versions= }} | 1 | |
| 14:56, 16 March 2011 | Pathology video.png (file) |  |
27 KB | {{Information |Description=logo for the Pathology section of WikiVideo |Source=WikiVet |Date=16/03/2011 |Author=CHris Trace |Permission=See below |Other_versions= }} | 1 |
| 13:32, 16 March 2011 | Anatomy video.png (file) |  |
28 KB | {{Information |Description=Logo for the Anatomy section of WikiVideo |Source=WikiVet |Date=16/03/2011 |Author=Chris Trace |Permission=See below |Other_versions= }} | 1 |
| 13:24, 16 March 2011 | Equine video.png (file) |  |
29 KB | {{Information |Description=Logo for Equine section of WikiVideo |Source=WikiVet |Date=16/03/2011 |Author=Chris Trace |Permission=See below |Other_versions= }} | 1 |
| 13:19, 16 March 2011 | Canine video.png (file) |  |
27 KB | {{Information |Description=logo for Canine section of WikiVideo |Source=WikiVet |Date=16/03/2011 |Author=Chris Trace |Permission=See below |Other_versions= }} | 1 |
| 13:14, 16 March 2011 | Bovine video.png (file) |  |
26 KB | {{Information |Description=Logo for Bovine video section of WikiVideo |Source=WikiVet |Date=16/03/2011 |Author=Chris Trace |Permission=See below |Other_versions= }} | 1 |
| 12:35, 16 March 2011 | WikiVideo.png (file) |  |
19 KB | {{Information |Description=WikiVideo logo |Source=Royal Veterinary College |Date=16/03/2011 |Author=Chris Trace |Permission=See below |Other_versions= }} | 1 |
| 11:46, 16 March 2011 | Oestrus ovis in sheep head.png (file) |  |
456 KB | {{Information |Description=A screenshot from the 'Oestrus ovis in the head of a sheep' video |Source=The Royal Veterinary College |Date=16/03/2011 |Author=Chris Trace |Permission=See below |Other_versi | 1 |
| 11:34, 16 March 2011 | CatSpay.png (file) |  |
539 KB | {{Information |Description=screenshot from Cat Spay video |Source=The Royal Veterinary College |Date=16/03/2011 |Author=Chris Trace |Permission=See below |Other_versions= }} | 1 |
| 11:04, 16 March 2011 | Equine Forelimb.png (file) |  |
632 KB | {{Information |Description=Screenshot of anatomy video of the equine forelimb |Source=RVC |Date=16/03/2011 |Author=Chris Trace |Permission=See below |Other_versions= }} | 1 |
| 20:41, 15 March 2011 | Introduction to Histology.png (file) |  |
836 KB | {{Information |Description=Screenshot of slide from Introduction to Histology ppt |Source=RVC |Date=15/03/2011 |Author=Chris Trace |Permission=See below |Other_versions= }} | 1 |
| 20:35, 15 March 2011 | Introduction to Histology.ppt (file) | 1.06 MB | {{Information |Description=An introductory PowerPoint tutorial on Histology |Source=Royal Veterinary College |Date=2009 |Author=John Bredl |Permission=See below |Other_versions= }} | 1 | |
| 12:58, 11 March 2011 | Vet school template.png (file) |  |
24 KB | {{Information |Description=screenshot of vet school editting template |Source=WikiVet |Date=11/03/2011 |Author=Chris Trace |Permission=See below |Other_versions= }} | 1 |
| 18:46, 10 March 2011 | Rodrigo.jpg (file) |  |
41 KB | {{Information |Description=picture of Rodrigo Nova |Source=Rodrigo |Date=Jan 2007 |Author=Rodrigo |Permission=See below |Other_versions= }} | 1 |
| 10:40, 1 March 2011 | David Hogg.jpg (file) |  |
20 KB | {{Information |Description=Headshot of David Hogg |Source=RVC |Date=01/03/2011 |Author=Chris Trace |Permission=See below |Other_versions= }} | 1 |
| 12:31, 23 February 2011 | Kate crop.jpg (file) |  |
61 KB | {{Information |Description=Kate English headshot |Source=RVC |Date=23/02/2011 |Author=Chris Trace |Permission=See below |Other_versions= }} | 1 |
| 10:58, 23 February 2011 | EquineLiverHydatidCyst.png (file) |  |
304 KB | {{Information |Description=A screenshot of a potcast featuring hydatid cysts in an equine liver |Source=http://stream2.rvc.ac.uk/Pathology/ParasitologyPots/PathPot_13_15.wmv |Date=23/02/2011 |Author=Chris Trace |Permission=See below |Other_versions= }} | 1 |
| 10:41, 23 February 2011 | CanineHead.png (file) |  |
305 KB | {{Information |Description=A screenshot of a Canine lateral head potcast |Source=http://stream2.rvc.ac.uk/Anatomy/canine/head_neck/Pot0220.wmv |Date=23/02/2011 |Author=Chris Trace |Permission=See below |Other_versions= }} | 1 |